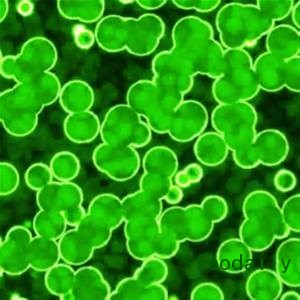

生物技术改善大豆品质
生物技术,特别是转基因技术引发了热议,有些人反对在农业中使用任何形式的生物技术。但正如 Galloway 和Associates 董事长兼Qualisoy及美国大豆委员会顾问Richard Galloway所解释,用于开发高油酸大豆油的生物技术,提供了许多好处。“使用生物技术开发新的大豆品种,为消费者增加了营养价值,如有益于心脏、大脑和免疫系统健康的油脂比例更高。同时它也创造了很多直接有益于食品行业的改进功能特性。对农民而言,生物技术提供的改进农艺特性能提高生产力,并更顾及到更多可持续农业实践。”邦吉和杜邦先锋的专家在分享对油脂配料的见解视频中说道。
站在产品开发的角度,测试表明,与其它商品油相比高油酸大豆油在高热应用中表现良好,Qualisoy指出,对餐饮经营商和食品生产商而言,油的抗氧化性和降低设备上聚合物的形成是魅力品质。Galloway继续说道,高油酸大豆油中更高的单不饱和脂肪酸是降低氧化敏感程度并因此减少异味及腐败的关键,从而延长其货架期。若适量摄入,单不饱和脂肪酸也可能有利于心脏健康,并有助于降低低密度脂蛋白胆固醇水平。
Galloway说,大豆植物逐一推动了构成大豆油脂肪酸的发展,首先是饱和脂肪酸,其次是单不饱和脂肪酸,接着是多不饱和脂肪酸。单不饱和脂肪酸,主要由油酸组成,抗氧化性比多不饱和脂肪酸强。他说:“杜邦先锋和孟山都均采用技术来阻止脂肪酸的遗传发展,所以开发油酸含量较高,而多不饱和脂肪酸含量较少的产品。”
就目前正在供应的高油酸大豆油而言,它于2011年被商业化,密苏里州切斯特菲尔德Qualisoy (qualisoy.com)预测2017年的年产值将达到约4亿磅,而2024年将达到93亿磅。美国种植大豆的农民超过一百万,为维护他们的切实利益,密苏里州切斯特菲尔德的美国大豆委员会(unitedsoybean.org)投资6000万美元来扩大高油酸大豆种子的发展。Galloway解释道:“这项投资是用来确保该种子品种可与市场上其它大豆种子匹敌。它也可以用来教育农民,树立对高油酸大豆的热情并促进食品工业中高油酸大豆油的发展。一旦最终获得欧盟(对孟山都公司而言,小部分监管步骤在中国完成)监管批准,杜邦先锋和孟山都随时准备扩大高油酸种子与精炼加工设备的开发。这些最终审批预计在今年完成。
杜邦先锋、约翰斯顿、爱荷华州(www.plenish.com)目前正提供Plenish高油酸大豆油。
微藻可产生功能性脂质
加利福尼亚州旧金山的Solazyme公司(algavia.com)利用在德国的板栗树液中发现的微藻菌株,开发了AlgaVia高稳定性藻油和AlgaVia超ω-9藻油。具体而言,该公司通过向藻类中植入产油植物的基因,帮助微藻将植物糖转化为油,从而提高了微藻的自然产油能力。“例如,开发有利于心脏健康的油时,我们可能会添加一个向日葵的基因以增加单不饱和脂肪酸的产量,同时切断藻类增加饱和脂肪酸产量的基因,”Solazyme公司高级副总裁兼食品原料总经理Mark Brooks解释说。“我们通过识别产油植物的最佳特性并将它们与藻类结合,从而增加食品配料的健康和营养益处。”他补充说,给微藻添加诸如玉米或甘蔗单糖,然后在不锈钢罐中发酵直到产生金色富油的细胞。该过程的下一个步骤是压榨微藻细胞出油,类似于某些植物油的生产,据Brooks说,这种油不包含任何转基因生物。该公司回收藻细胞。

这两种AlgaVia藻油各有具体应用,可以发挥其最佳效用。由于具有高氧化稳定性和保质期长特点,AlgaVia高稳定性藻油很适用于油炸产品,可以替换或减少调味料、薯片、炸薯条和蛋黄酱中的饱和脂肪酸和反式脂肪酸(该油反式脂肪酸含量为0g)。Brooks还指出,由于该油味道中性,它可以作为敏感应用中的风味载体或保护剂或者与其它油混合。正如其名称所表明的,AlgaVia超ω-9藻油是单不饱和ω-9脂肪的丰富来源,是制造商 “用有益心脏健康的单不饱和脂肪酸”减少或取代包装食品中饱和脂肪酸的一种替代配料。Brooks说。“该油独特的品质是其485°F的高发烟点,超过了橄榄油、黄油、菜籽油、棕榈油和大豆油,并由于其完全中性的味道,它可以让你在进食时品尝你的食物,而不会被另一种味道所掩盖。”
藻油不是Solazyme公司提供的唯一一种微藻基脂质配料;其AlgaVia全藻类面粉是一种不含反式脂肪、胆固醇并且富含单不饱和脂肪酸的配料,它可以减少或替代乳品脂肪、蛋黄和油。“由于其顺滑、奶油般的质地和中性味道,它相对其他脂类替代品是独一无二的,”Brooks声明说。该配料还有助于减少热量和饱和脂肪酸。Brooks对此特别提出的一个例子是辫子面包的产品概念,AlgaVia全藻粉代替了所有的鸡蛋和一些油,从而减少了60%的总脂肪,降低20%的热量,并减少了100%的饱和脂肪酸和胆固醇。
低饱和度起酥油

位于美国密苏里州圣路易斯市的Bunge North America公司(Bunge North America, St. Louis, Mo.)通过使用酶促酯交换法等技术手段对大豆、芥花油籽、油菜籽以及葵花籽进行加工得到了饱和脂肪含量较低并且不含反式脂肪的食用油、人造黄油以及起酥油。Bunge公司发明了一种新的专利技术,该技术可重新排列甘油主链上的脂肪酸,生产出饱和脂肪酸含量较低的塑性脂肪,并且还可保证其在室温条件下能够具有稳定的结构和功能特性。向脂肪中添加纤维素粉可以为液态油形成晶体结构提供额外的力的支持。该公司将该项技术称为饱和脂肪酸去除技术,并且运用该技术生产出了UltraBlends Designer Solutions 148万能起酥油、UltraBlends Designer Solutions 172万能烘焙起酥油以及UltraBlends Designer Solutions 358乳化烘焙起酥油。根据公司的介绍,这些起酥油的饱和脂肪含量低,并且都不含反式脂肪,与传统的起酥油相比,这些产品的单不饱和脂肪酸和多不饱和脂肪酸含量都较高。除此之外,该公司还开发了其他一些技术,例如可以将大豆油和棉籽油中的反式脂肪和饱和脂肪降低30%的RighT技术,还有NH技术,该项技术可以将棕榈或是棕榈仁开发成零反式脂肪的起酥油,这样就可以使生产商们去除终产品标签上氢化物的标注。
Bunge公司其他类型的食用油、涂抹酱以及起酥油还可以为全世界的消费者提供营养和功能强化方面的帮助。公司现在正在继续研发新的技术,以期优化其油脂配料中ω-3脂肪酸、ω-6脂肪酸、单不饱和脂肪酸以及多不饱和脂肪酸的含量,并且希望能够提供反式脂肪的替代品。该公司还对植物甾醇、纤维素以及其他配料进行了开发生产出了功能性食品。最近几年,公司已经相继推出了Floriol Iod Protect(一种可以帮助罗马尼亚地区预防碘缺乏症的加碘葵花籽油)以及Delicia Light(一种在巴西销售的不含部分氢化油的人造黄油)等产品。该公司其他的一些产品还包括Phytobake(一种不含部分氢化油并且使用植物甾醇代替饱和脂肪的在北美地区销售的烘焙起酥油) ,Douweijia Smart Quality Blended Oil(一种可以帮助中国消费者提高ω-3脂肪酸摄入量的添加了DHA的大豆油和葵花籽油调和油)。
油脂配料综述
想要寻找反式脂肪酸的替代品或是更稳定的油吗?为了你的产品开发计划,请考虑以下改进与加强的建议。
· 瑞典Malmö市的AAK集团(aak.com)专为巧克力及糖果工业生产与供应特种植物油脂。他们的配料包括:可可脂替代物以及具有附加功能的馅料油等。乳木果油、雾冰草脂、棕榈油及其他油脂被用作开发这些配料的原材料。
· 非转基因项目(The Non GMO Project)在2015年二月对来自明尼苏达州St. Paul市CHS集团的一系列非转基因大豆配料进行了非转基因认证。其中包括两种油类配料,CHS大豆色拉油和CHS大豆原油。
· 印第安纳州 印第安纳波利斯市的Dow AgroSciences公司(dowagro.com, omega-9oils.com)提供ω-9菜籽油与ω-9葵花籽油,它们富含单不饱和脂肪酸并且含有很少的多不饱和脂肪,因此在使用该油油炸时可以产生的多聚物更少。
· 智利圣地亚哥的 Functional Product Trading S.A公司(benexia.com)在2014年欧洲健康食品配料&天然配料展(HiE, Hi Europe,Ni& NuW)上宣布,其Benexia奇亚籽油被欧盟(UE)选定为用于植物油脂(最多10%)及食品补充剂(2g/天)的新型食品。
· 加拿大萨斯喀彻温省萨斯卡通市North Prairie Family Farms公司(northprairiefamilyfarms.com)种植加拿大油菜(canola),用于生产North Prairie Gold Canadian芥花油,它是萨斯卡通市Virtex Farm Foods公司(virtexfoods.com)的产品。冷压过程的温度不超过50°F,有帮于保留油的琥珀色及轻微的坚果风味。该公司在2015年美国天然原料、有机产品展览会(2015 Natural Products West/Engredea show)上推出此产品。
· 希望在减少饱和脂肪酸含量的同时增加单不饱和脂肪酸和多不饱和脂肪酸的食品开发商和餐饮经营者可以转向芥花油。加拿大马尼托巴省温尼伯市的Richardson Oilseed公司(richardson.ca)生产与供应芥花油及芥花与蔬菜调和油,可以直接应用于油配料、人造奶油、起酥油与喷雾剂。该公司还提供使用传统方式培育的种籽经冷压的压榨芥花油,以及拥有高油酸、低亚麻酸的特殊芥花油,这种油在油炸锅中像液体起酥油,它可以作为传统油脂的非氢化替代物。
· 田纳西州孟菲斯市的Stratas Foods公司(stratasfoods.com)最近推出了Sustain油。它由中油酸与高油酸的葵花籽油混合而成,据公司称,它为制造商提供了新的选项,因为它不含反式脂肪酸,拥有较长的油炸寿命,由于产生很少聚合物及胶而使油炸锅的清洁非常容易,并且它的口味很清淡。


评论